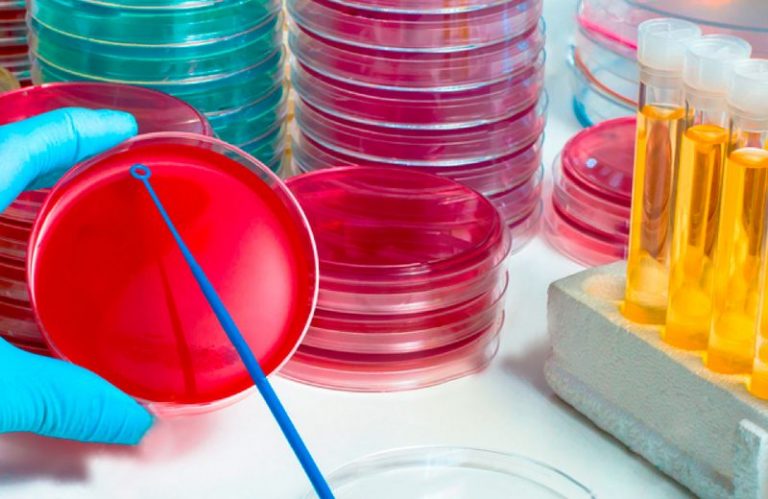

(*) Brendan Tindall, Graham Vesey
Tradução: Maria Fernanda Areal e Marco Aurélio Floriano Piantola (*)
O teste de promoção de crescimento de meios de cultura é uma parte importante dos testes microbiológicos em apoio à qualidade farmacêutica (1). O teste de promoção de crescimento é um requisito de controle de qualidade que confirma a capacidade de um novo lote de meio de cultura para garantir o crescimento de uma seleção predeterminada de microrganismos representativos. Todos os meios utilizados em uma instalação que segue as BPFs devem ser testados, incluindo os meios para limites microbianos, monitoramento ambiental e testes de esterilidade (2,3). Os requisitos de teste de promoção de crescimento aplicam-se a meios produzidos internamente e adquiridos externamente (3,4).
Método de diluições versus materiais referência
Os materiais microbiológicos de referência, são disponibilizados atualmente por vários fornecedores para diversas regiões, em formatos qualitativos e quantitativos. Os materiais de referência quantitativos contêm um número definido de micro-organismos viáveis e são normalmente uma suspensão liofilizada ou gel fornecida com um Certificado de Análise (CA) especificando o número de microrganismos viáveis que devem ser recuperados. Antes da disponibilidade de materiais de referência de alta qualidade, o teste de promoção de crescimento era geralmente realizado plaqueando uma suspensão de micro-organismo diluída em série em um novo lote de meios de cultura e em um lote previamente aprovado, visando comparar as recuperações. Esse método mostrou-se difícil na obtenção de resultados precisos (5). Além disso, esta abordagem é potencialmente falha, pois o inóculo não vem com um CA e um declínio gradual na viabilidade pode não ser prontamente detectado. O teste com um material de referência fornece um ponto de calibração externo independente e preciso. Cada lote de material de referência pronto para uso deve provir de um fabricante acreditado na norma ISO 17034: 2016 e oferecer dados quantitativos específicos para o lote no CA (6). O CA deve reportar uma contagem média de unidades formadoras de colônia (UFC) e o desvio padrão para cada lote.
Materiais de referência certificados têm sido amplamente utilizados em química analítica há muitas décadas, mas só estão disponíveis para microbiologistas nos últimos anos (7). Um material de referência certificado é um material de referência caracterizado por um procedimento metrologicamente válido para uma ou mais propriedades específicas, acompanhado por um certificado que declara o valor da propriedade especificada, sua incerteza de medição associada e uma declaração de rastreabilidade metrológica (8). A rastreabilidade metrológica é a propriedade de um resultado de medição pelo qual o resultado pode ser relacionado a uma referência através de uma cadeia ininterrupta de calibrações documentada, cada uma contribuindo para a incerteza de medição (9). Isso significa que, ao usar um resultado de medição com rastreabilidade metrológica, como a contagem média de UFCs de um material de referência certificado credenciado para sua quantificação, as medições podem ser comparadas de maneira significativa mesmo quando são feitas em diferentes momentos e lugares por pessoas diferentes ou usando equipamentos diferentes (10). Para métodos quantitativos tais como testes de promoção de crescimento, um material de referência certificado que tenha um valor de propriedade quantitativo, tal como UFCs, melhoraria ainda mais a capacidade de alcançar resultados comparáveis de acordo com os requisitos da farmacopeia.
Durante a fabricação farmacêutica, cada instalação deve realizar o monitoramento ambiental que mede e monitora os níveis de biocarga microbiana (11). Tendo em mente que as farmacopéias não estão harmonizadas para o monitoramento ambiental e cada uma possui requisitos variados que exigem taxas muito baixas de recuperação inicial de contaminação ou a detecção de níveis muito baixos de UFCs (Tabelas 1 e 2). Os requisitos variam dependendo da criticidade da área de fabricação para a esterilidade do produto. Dependendo da classificação da sala limpa, pode haver requisitos muito rigorosos sobre o resultado do monitoramento ambiental.
Por exemplo, em salas como a ISO 5 e 6, as contagens de UFC permitidas são extremamente baixas e precisam ser gerenciadas muito de perto. Na USP <1116> Controle Microbiológico e Monitoramento de Ambientes de Processamento Asséptico, afirma que as taxas de recuperação inicial de contaminação sugeridas para ambientes assépticos em salas ISO 5 e ISO 6 devem mostrar apenas contaminação em placas de controle <1% e <3% dos tempos, respectivamente (12). Isso significa que, pelo menos, 97% do tempo, não há crescimento esperado. Além disso, nas “Diretrizes da UE para Boas Práticas de Fabricação de Medicamentos para Uso Humano e Veterinário Anexo 1 Fabricação de Medicamentos Estéreis” é muito claro sobre os números de UFC recomendados como limites de contaminação microbiana (13).
Tabela 1: Taxas de Recuperação da Contaminação Inicial Sugeridas em Ambientes Assépticos pela USP <1116>
| Classificação da sala | Amostragem ativa de ar (%) | Exposição passiva de placa de 9cm por 4h (%) | Placas de contato e Swab (%) | Luvas e roupas (%) |
| Isolador (ISO 5 ou melhor) | <0.1 | <0.1 | <0.1 | <0.1 |
| ISO 5 | <1 | <1 | <1 | <1 |
| ISO 6 | <3 | <3 | <3 | <3 |
# Todos os operadores estão vestidos de forma asséptica nesses ambientes (com exceção dos ambientes de fundo para isoladores). Essas recomendações não se aplicam a áreas de produção de produtos não estéreis ou outros ambientes classificados nos quais não são usados aventais totalmente assépticos.
Tabela 2: Diretrizes europeias presentes no Anexo 1 da EUPh
| Grau | Amostragem de ar (UFC/m3) | Exposição de placa de 9cm por 4h (UFC/placa) | Placas de contato de 55 mm (UFC/placa) | Impressão dos 5 dedos da luva (UFC/luva) |
| A | <1 | <1 | <1 | <1 |
| B | 10 | 5 | 5 | 5 |
| C | 100 | 50 | 25 | – |
| D | 200 | 100 | 50 | – |
Por exemplo, ao considerar placas de contato para salas de Grau A e B (ISO 5 e 6), <1 e <5 colônias devem ser recuperadas. Estes são números muito pequenos de UFCs, implicando que as placas de contato devem ser capazes de recuperar e crescer um pequeno número de micro-organismos. Consequentemente, os usuários precisam ter confiança na qualidade, especialmente no desempenho da fertilidade, do meio de cultura usado. Estudos recentes realizados em monitoramento ambiental de superfícies mostraram variação na recuperação de micro-organismos entre as superfícies amostradas (14). Outro estudo encontrou discrepâncias entre os fornecedores de placas de contato, levando a erros aleatórios e sistemáticos (15). É importante ter muita confiança no desempenho do meio de cultura utilizado.
O que a Farmacopéia Americana (USP) diz?
Os requisitos do teste de promoção de crescimento da USP para meios de cultura sólidos e líquidos são descritos no capitulo <61> como: “Para meios sólidos, o crescimento obtido não deve diferir um fator superior a 2 do valor calculado para um inóculo padronizado. Para inóculo recém-preparado, a contagem do crescimento dos micro-organismos deve ser comparável àquela anteriormente obtida com um lote previamente testado e aprovado. Os meios líquidos são aprovados se ocorre o crescimento claramente visível dos micro-organismos comparável ao crescimento obtido em um lote de meio previamente testado e aprovado “(1). A USP também estipula usar menos de 100 UFCs. Um fator de 2 é comumente interpretado como uma recuperação de 50 a 200%, senão metade ou o dobro da contagem de UFCs do inóculo original do teste de promoção de crescimento. No caso de testes de promoção de crescimento, essa comparação está entre as UFCs do meio previamente testado e do novo lote de meio, por exemplo, se o lote anterior de meios testados tivesse 50 UFCs, o novo lote de meio deve ter >25 e <100 UFCs para passar. Esta abordagem permite entre 25 a 100 UFCs, o que poderia ser uma variação de até 75 UFCs entre as placas e ainda ter um teste de promoção de crescimento com resultado satisfatório. Este amplo critério de aceitação permite a variação no inóculo, particularmente se o inóculo for preparado por diluição seriada. A menos que monitorado de perto, a comparação de lotes anteriores pode resultar em declínio progressivo no desempenho da mídia, levando ao possível aceitação de meios de cultura menos férteis (16). Por esta razão, critérios de aceitação que também incluem resultados baseados em preparos padronizados de micro-organismos trazem muito mais confiança aos resultados de testes de promoção de crescimento.
Conclusão
- Use um material de referência acreditado ISO17034: 2016 para crescimento teste de promoção
- Escolha um material de referência ou material certificado com o menor desvio padrão para aumentar a capacidade de observar mudanças na fertilidade dos meios.
- Selecione um material de referência ou material de referência certificado com consistência de lote em níveis de UFCs
- Garanta o uso de um material de referência que corresponda ao descrito no CA
- Compare a contagem UFC especificada no CA com os resultados do teste de promoção de crescimento e defina níveis internos de recuperação (para meios não seletivos)
- Monitore tendências em resultados de promoção de crescimento para procurar descontinuidades ou variações na fertilidade dos meios ao longo do tempo
Com a atual disponibilidade de materiais de referência certificados de alta qualidade, precisão e acurácia, consequentemente podem ser alcançados resultados mais precisos e acurados que permitem a qualificação de novos lotes de meios de cultura com um alto grau de confiança.
Referências
- USP <61> Microbiological examination of non-sterile products: microbial enumeration tests
- USP <1117> Microbiological best laboratory practices
- Guidance for Industry: Sterile Drug Products Produced by Aseptic Processing — Current Good Manufacturing Practice, U.S. FDA, September 2004
- Pharmaceutical Microbiology Manual, U.S. FDA, 2014
- Sutton, S. “Accuracy of Plate Counts.” Journal of Validation Technology 17 (2011): 42–48.
- ISO17034:2016 General requirements for the competence of reference material producers
- Fajgelj, A. 2000 Using Certified Reference Materials in Analytical Chemistry – Present Status, Trends and Needs. Spectroscopy 15 (2000): 19–21.
- ISO Guide 30:2015 Clause 2.1.2
- VIM3 Clause 2.41 metrological traceability
- Armishaw, P. “Certified Reference Materials – A Path to Traceable Chemical Measurements.” Presented at the Australian National Measurement Institute May 5, 2016.
- Peacos, P. “Using Contamination Rates For Environmental Monitoring Trending-It’s Not Just For Clean Rooms.” American Pharmaceutical Review (February 16, 2016)
- USP <1116> Microbiological control and monitoring of aseptic processing environments
- EU Guidelines to Good Manufacturing Practice Medicinal Products for Human and Veterinary Use – Annex 1 Manufacture of Sterile Medicinal Products – 2008
- Goverde M, et al,. “Evaluation of the Recovery Rate of Different Swabs for Microbial Environmental Monitoring.” PDA Journal of Pharmaceutical Science and Technology 71 (2017): 33–42.
- Grosselin, J., “Quantitative evaluation of microorganisms recovery from surfaces using contact plates.” Presented at the European Microbiology Conference, Vienna, April 2018.
- Guidelines for Assuring Quality of Medical Microbiological Culture Media. July 2012. Culture Media Special Interest Group for the Australian Society for Microbiology, Inc.
(*) Brendan Tindall é Gerente Global de Soluções e Diretor de Programas na bioMérieux
Graham Vesey é CSO (Chief Scientific Officer) da Regeneus Ltd.
Maria Fernanda Areal é Mestre em Ciência de Alimentos pela UFRJ e Gerente de Marketing Indústria da bioMérieux
Marco Aurélio Floriano Piantola é Assessor Científico da bioMérieux.